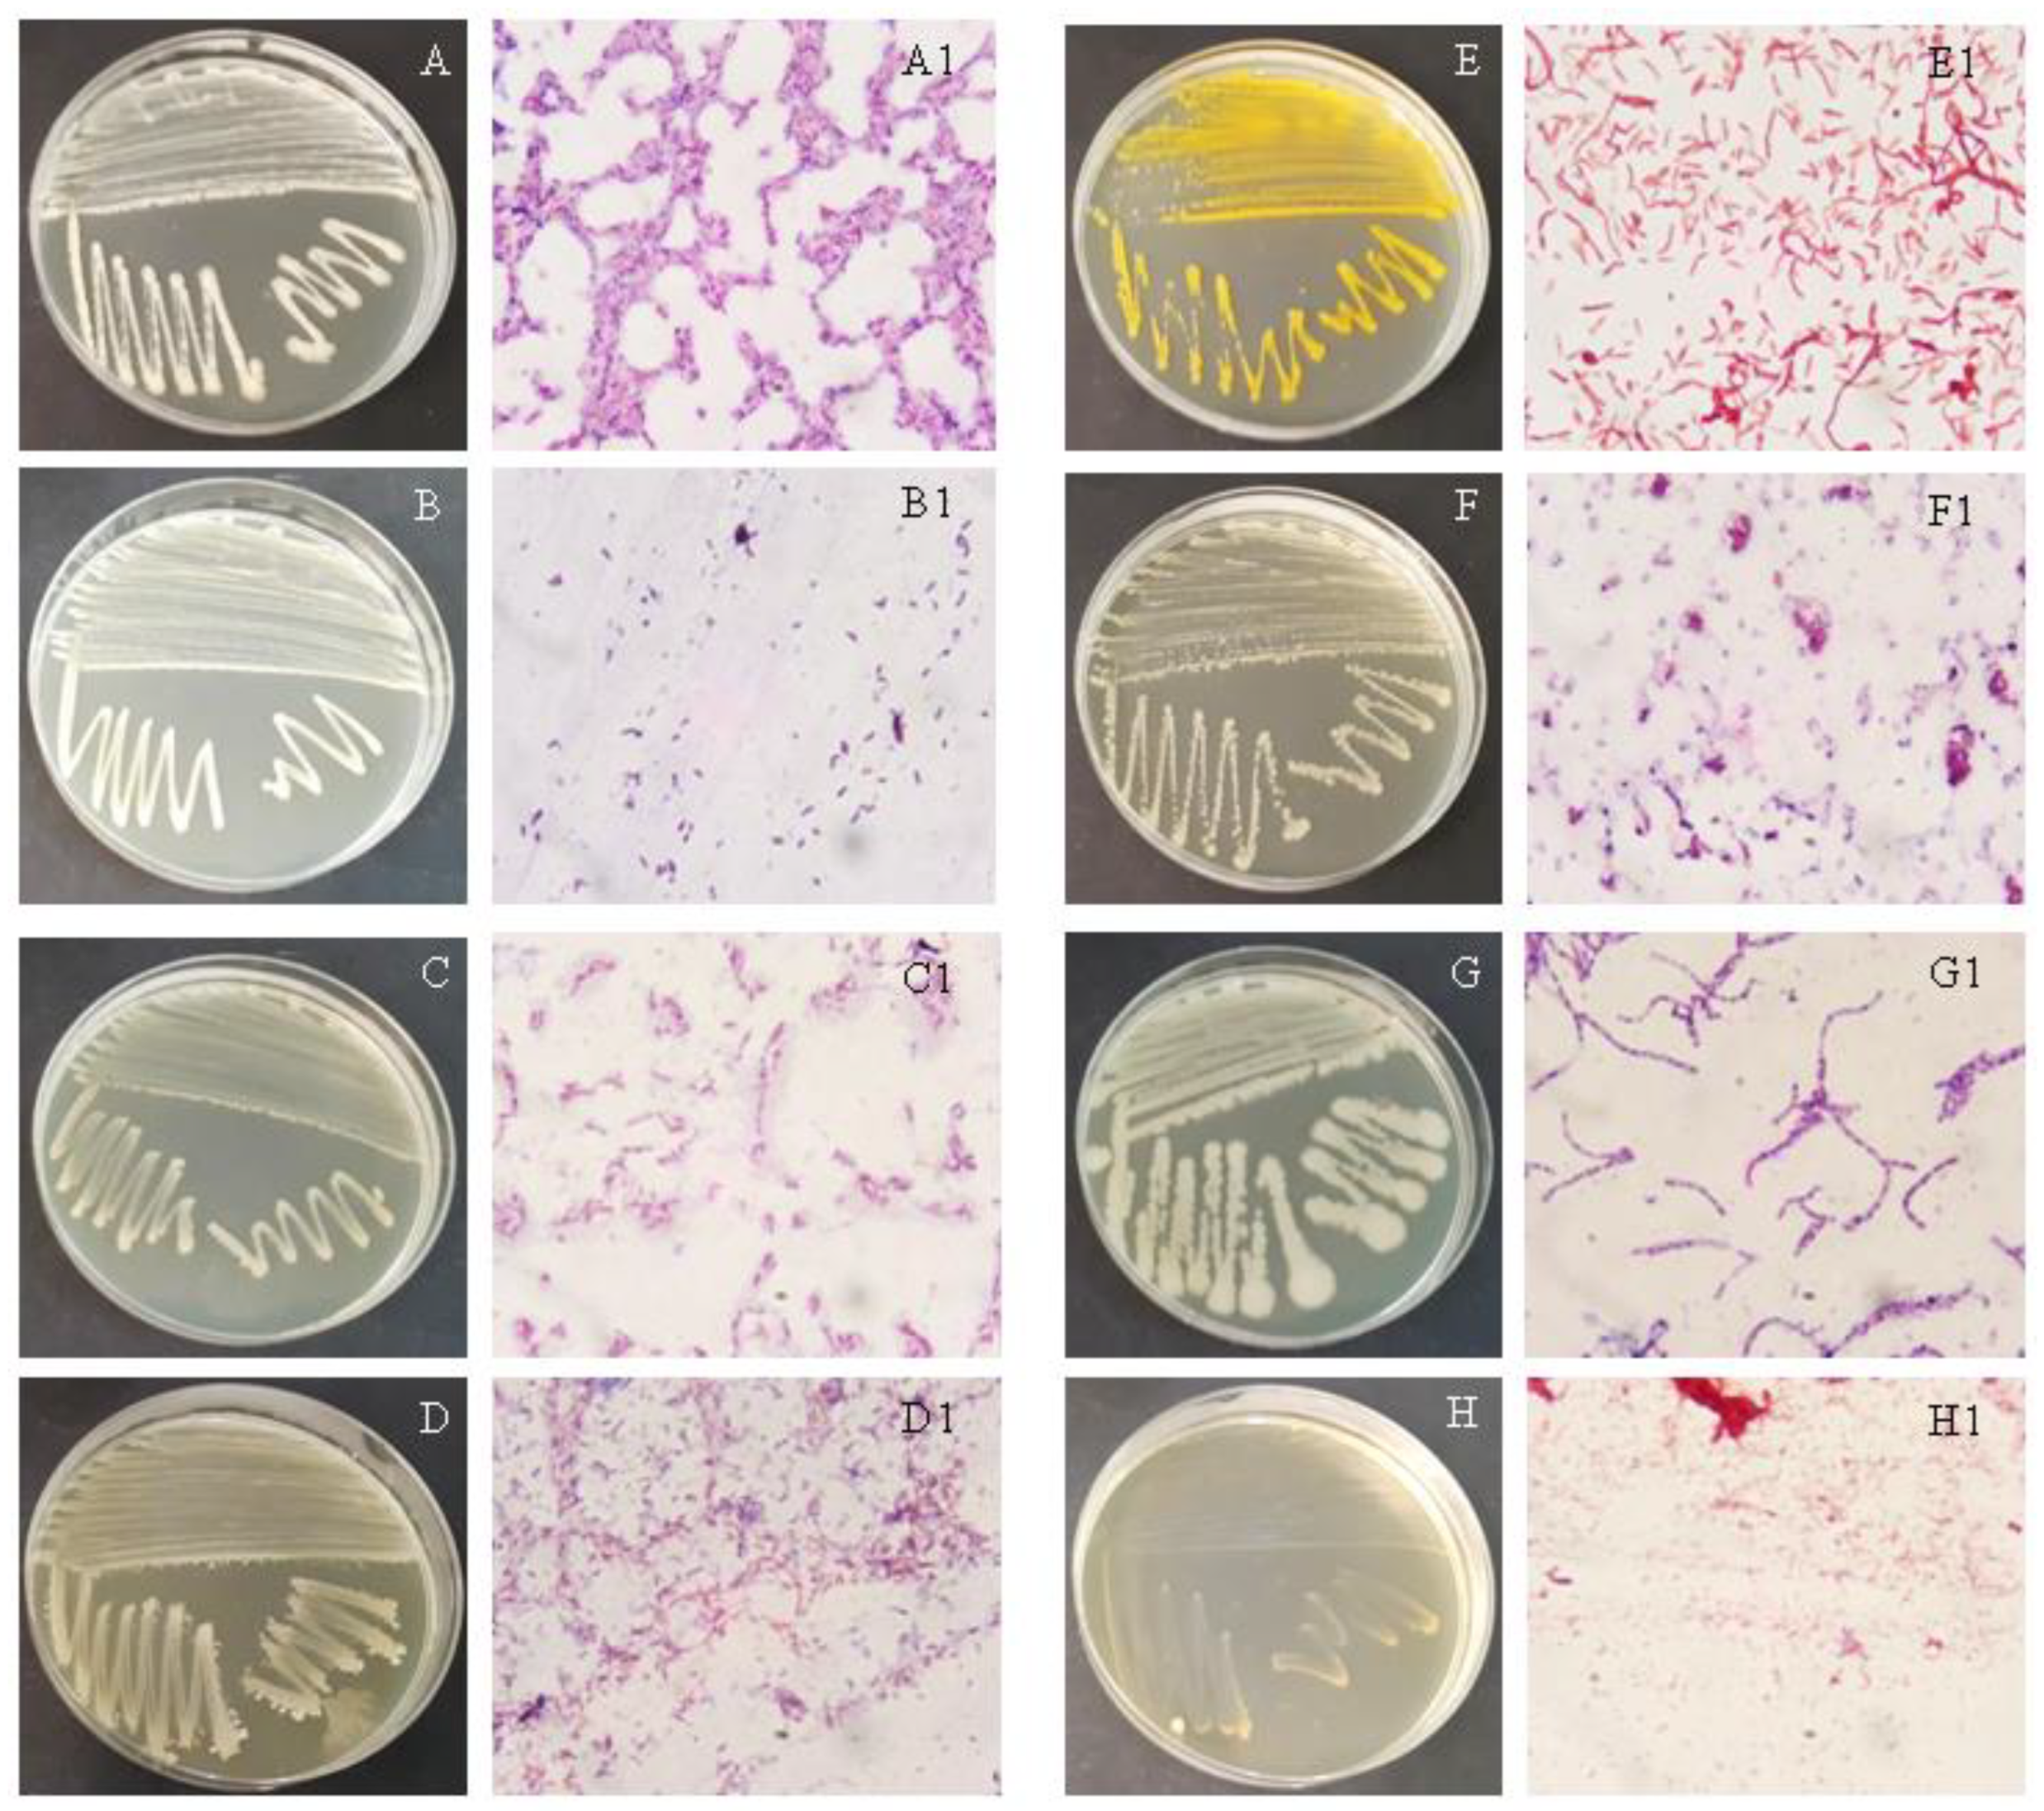
Separations 10 00079 g002 Separations 10 00079 g002

Screening the Efficacy of a Microbial Consortium of Bacteria and Fungi Isolated from Different Environmental Samples for the Degradation of LDPE/TPS Films
Abstract
1. Introduction
2. Materials and Methods
2.1. Polymer Materials
2.2. Environmental Samples
2.3. Isolation of Microorganisms from the Environment Samples
2.4. Identification of Isolated Cultures
2.5. Screening of Polymer-Degrading Bacteria and Fungi
2.5.1. Light Microscopy
2.5.2. Scanning Electron Microscopy
2.5.3. FTIR Spectroscopy
3. Results and Discussion
3.1. Isolation and Identification of Microorganisms
3.2. Biodegradation of Polymer Materials
4. Conclusions
Author Contributions
Funding
Institutional Review Board Statement
Informed Consent Statement
Data Availability Statement
Conflicts of Interest
References
- Sangale, M.K.; Shahnawaz, M.; Ade, A.B. A review on biodegradation of polythene: The microbial approach. J. Bioremed. Biodegrad. 2012, 3, 164. [Google Scholar] [CrossRef]
- Wilkes, R.A.; Aristilde, L. Degradation and metabolism of synthetic plastics and associated products by Pseudomonas sp.: Capabilities and challenges. J. Appl. Microbiol. 2017, 123, 582–593. [Google Scholar] [CrossRef] [PubMed]
- Auta, H.S.; Emenike, C.U.; Fauziah, S.H. Screening of Bacillus strains isolated from mangrove ecosystems in Peninsular Malaysis for microplastic degradation. Environ. Pollut. 2017, 231, 1552–1559. [Google Scholar] [CrossRef] [PubMed]
- Carr, S.A.; Liu, J.; Tesoro, A.G. Transport and fate of microplastic particles in wastewater treatment plants. Water Res. 2016, 91, 174–182. [Google Scholar] [CrossRef] [PubMed]
- Geyer, R.; Jambeck, J.R.; Law, K.L. Production, use, and fate of all plastic ever made. Sci. Adv. 2017, 3, e1700782. [Google Scholar] [CrossRef] [PubMed]
- Boucher, C.; Morin, M.; Bendell, L.I. The influence of cosmetic microbeads on the sorptive behavior of cadmium and lead within intertidal sediments: A laboratory study. Reg. Stud. Mar. Sci. 2016, 3, 1–7. [Google Scholar] [CrossRef]
- Miloloža, M.; Kučić Grgić, D.; Bolanča, T.; Ukić, Š.; Cvetnić, M.; Ocelić Bulatović, V.; Dionysiou, D.D.; Kušić, H. Ecotoxicological assessment of microplastics in freshwater sources—A review. Water 2021, 13, 56. [Google Scholar] [CrossRef]
- Miloloža, M.; Bule, K.; Prevarić, V.; Cvetnić, M.; Ukić, Š.; Bolanča, T.; Kučić Grgić, D. Assessment of the influence of size and concentration on the ecotoxicity of microplastics to microalgae Scenedesmus sp., bacterium Pseudomonas putida and yeast Saccharomyces cerevisiae. Polymers 2022, 14, 1246. [Google Scholar] [CrossRef]
- Bajsic, E.G.; Persic, A.; Jemric, T.; Buhin, J.; Kucic Grgic, D.; Zdraveva, E.; Zizek, K.; Holjevac Grguric, T. Preparation and characterization of polyethylene biocomposites reinforced by rice husk: Application as potential packaging material. Chemistry 2021, 3, 1344–1362. [Google Scholar] [CrossRef]
- Moustafa, H.; Guizani, C.; Dufresne, A. Sustainable biodegradable coffee grounds filler and its effect on the hydrophobicity, mechanical and thermal properties of biodegradable PBAT composites. J. Appl. Polym. Sci. 2016, 134, 44498. [Google Scholar] [CrossRef]
- Ocelić Bulatović, V.; Borković, I.; Kučić Grgić, D.; Jozinović, A. Thermal and mechanical properties of thermoplastic starch blends. Chem. Ind. 2018, 67, P21–P31. [Google Scholar] [CrossRef]
- Ocelić Bulatović, V.; Kučić Grgić, D.; Mandić, V.; Miloloža, M.; Dybal, J.; Gajdosova, V.; Slouf, M. Biodegradation of LDPE_TPS blends under controlled composting conditions. Polym. Bull. 2022, 177. [Google Scholar] [CrossRef]
- Rani, R.; Rathee, J.; Kumari, P.; Singh, N.P.; Santal, A.R. Biodegradation and detoxification of low-density polyethylene by an indigenous strain Bacillus licheniformis. J. Appl. Biol. Biotech. 2022, 10, 9–21. [Google Scholar] [CrossRef]
- Abioye, A.A.; Obuekwe, C.C. Investigation of the biodegradation of low-density polyethylene-starch bi-polymer blends. Results Eng. 2020, 5, 100090. [Google Scholar] [CrossRef]
- Tena-Salcido, C.S.; Rodríguez-González, F.J.; Méndez-Hernández, M.L.; Contreras-Esquivel, J.C. Effect of morphology on the biodegradation of thermoplastic starch in LDPE/TPS blends. Polym. Bull. 2008, 60, 677–688. [Google Scholar] [CrossRef]
- Kale, S.K.; Deshmukh, A.G.; Dudhare, M.S.; Patil, V.B. Microbial degradation of plastic: A review. J. Biochem. Technol. 2015, 6, 952–961. [Google Scholar]
- Venkatesh, S.; Mahboob, S.; Govindarajan, M.; Al-Ghanim, K.A.; Ahmed, Z.; Al-Mulhm, N.; Gayathri, R.; Vijayalakshmi, S. Microbial degradation of plastics: Sustainable approach to tackling environmental threats facing big cities of the future. J. King Saud Univ. Sci. 2021, 33, 101362. [Google Scholar] [CrossRef]
- Kučić Grgić, D.; Bera, L.; Miloloža, M.; Cvetnić, M.; Ignjatić Zokić, T.; Miletić, B.; Leko, T.; Ocelić Bulatović, V. Treatment of active mud from urban wastewater treatment plants using the composting process. Hrvat. Vode 2020, 28, 1–8. [Google Scholar]
- Yan, S.; Subramanian, B.; Surampalli, R.Y.; Narasiah, S.; Tyagi, R.D. Isolation, characterization and identification of bacteria from activated sludge and soluble microbial products in wastewater treatment systems. Pract. Period. Hazard. Toxic Radioact. Waste Manag. 2007, 11, 240–258. [Google Scholar] [CrossRef]
- Sharifi-Yazdi, M.K.; Azimi, C.; Khalili, M.B. Isolation and identification of bacteria present in the activated sludge unit, in the treatment of industial waste water. Iranian J. Publ. Health 2001, 30, 91–94. [Google Scholar]
- Bhumbla, U.; Majumdar, S.; Jain, S.; Dalal, A.S. A study of isolation and identification of bacteria from lake water in and around Udaipur, Rajasthan. J Family Med Prim Care. 2020, 9, 751–754. [Google Scholar] [CrossRef] [PubMed]
- Spring, S.; Schulze, R.; Overmann, J.; Schleifer, K.-H. Identification and characterization of ecologically significant prokaryotes in the sediment of freshwater lakes: Molecular and cultivation studies. FEMS Microbiol. Rev. 2000, 24, 573–590. [Google Scholar] [CrossRef] [PubMed]
- Gogoi, G.; Sharma, P.; Buragohain, P.; Phukan, A.; Baruah, R. Isolation and characterization of compost accelerating microbes. Biosci. Trends 2015, 8, 5854–5859. [Google Scholar]
- Kučić Grgić, D.; Vuković Domanovac, M.; Domanovac, T.; Šabić, M.; Cvetnić, M.; Ocelić Bulatović, V. Influence of Bacillus subtilis and Pseudomonas aeruginosa BSW and clinoptilolite addition on the biowaste composting process. Arab. J. Sci. Eng. 2019, 44, 5399–5409. [Google Scholar] [CrossRef]
- Briški, F.; Kopčić, N.; Ćosić, I.; Kučić, D.; Vuković, M. Biodegradation of tobacco waste by composting: Genetic identification of nicotine-degrading bacteria and kinetic analysis of transformations in leachate. Chem. Pap. 2012, 66, 1103–1110. [Google Scholar] [CrossRef]
- Benson, H.J. Microbiological Applications, A Laboratory Manual in General Microbiology, 8th ed.; The McGraw-Hill Companies: New York, USA, 2001; pp. 154–156,160,168,169. [Google Scholar]
- Smith, G.; Onions, A.H.S.; Allsopp, D.; Eggins, H.O.W. Smith’s Introduction to Industrial Mycology, 7th ed.; Edward Arnold: London, UK, 1981; pp. 1–398. [Google Scholar]
- Kyaw, B.M.; Champakalakshmi, R.; Sakharkar, M.K.; Lim, C.S.; Sakharkar, K.R. Biodegradation of low density polyethylene (LDPE) by Pseudomonas species. Indian J. Microbiol. 2012, 52, 411–419. [Google Scholar] [CrossRef] [PubMed]
- Black, J.G. Microbiology: Principles and Explorations, 8th ed.; John Wiley & Sons: Hoboken, NJ, USA, 2012; pp. 68–71. [Google Scholar]
- Silhavy, T.J.; Kahne, D.; Walker, S. The bacterial cell envelope. Cold Spring Harb. Perspect. Biol. 2010, 2, a000414. [Google Scholar] [CrossRef] [PubMed]
- Yousif, M.Q.; Qasem, S.A. Tissue Processing and staining for histological analyses, Chapter 3. In Skin Tissue Engineering and Regenerative Medicine, 1st ed.; Albanna, M.Z., Holmes, J.H., Eds.; Elsevier: New York, NY, USA, 2016; pp. 49–59. [Google Scholar] [CrossRef]
- Oktari, A.; Supriatin, Y.; Kamal, M.; Syafrullah, H. The bacterial endospore stain on Schaeffer Fulton using variation of methylene blue solution. J. Phys. Conf. Ser. 2017, 812, 012066. [Google Scholar] [CrossRef]
- Pepper, I.L.; Gerba, C.P.; Gentry, T.J. Environmental Microbiology, Chapter 2. In Microorganisms Found in the Environment, 3rd ed.; Elsevier: New York, NY, USA, 2015; pp. 9–33. [Google Scholar] [CrossRef]
- Sue, D.; Hoffmaster, A.R.; Popovic, T.; Wilkins, P.P. Capsule production in Bacillus cereus strains associated with severe pneumonia. J. Clin. Microbiol. 2006, 44, 3426–3428. [Google Scholar] [CrossRef]
- Singhal, N.; Kumar, M.; Kanaujia, P.K.; Virdi, J.S. MALDI-TOF mass spectrometry: An emerging technology for microbial identification and diagnosis. Front. Microbiol. 2015, 6, 791. [Google Scholar] [CrossRef]
- Anbu, S.; Saranraj, P.; Padma, J. Synergetic effect of microbially fermented soybean and NPK fertilizer on plant growth of grand naine banana. J. Acad. Ind. Res. 2017, 6, 27–31. [Google Scholar]
- Du, Y.; Xu, Z.; Yu, G.; Liu, W.; Zhou, Q.; Yang, D.; Li, J.; Chen, L.; Zhang, Y.; Xue, C.; et al. A newly isolated Bacillus subtilis strain named WS-1 inhibited diarrhea and death caused by pathogenic Escherichia coli in newborn piglets. Front. Microbiol. 2019, 10, 1248. [Google Scholar] [CrossRef] [PubMed]
- Park, S.Y.; Kim, C.G. Biodegradation of micro-polyethylene particles by bacterial colonization of a mixed microbial consortium isolated from a land site. Chemosphere 2019, 222, 527–533. [Google Scholar] [CrossRef]
- Garcha, S.; Verma, N.; Brar, S.K. Isolation, characterization and identification of microorganisms from unorganized dairy sector wastewater and sludge samples and evaluation of their biodegradability. Water Res. Ind. 2016, 16, 19–28. [Google Scholar] [CrossRef]
- Kalaivani, S.; Kumar Sahu, A.; Shanthi, K. Screening and isolation of effective microbes from organic wastes for faster and effective degradation of bio-degradable municipal solid waste. In Proceedings of the International Conference on Green Technology and Environmental Conservation, Chennai, India, 15–17 December 2011; pp. 162–166. [Google Scholar] [CrossRef]
- Trofa, D.; Gacser, A.; Nosanchuk, J.D. Candida parapsilosis, an emerging fungal pathogen. Clin. Microbiol. Rev. 2008, 21, 606–625. [Google Scholar] [CrossRef] [PubMed]
- Neji, S.; Hadrich, I.; Trabelsi, H.; Abbes, S.; Cheikhrouhou, F.; Sellami, H.; Makni, F.; Ayadi, A. Virulence factors, antifungal susceptibility and molecular mechanisms of azole resistance among Candida parapsilosis complex isolates recovered from clinical specimens. J. Biomed. Sci. 2017, 24, 67. [Google Scholar] [CrossRef]
- Mor, R.; Sivan, A. Biofilm formation and partial biodegradation of polystyrene by the actinomycete Rhodococcus ruber. Biodegradation 2008, 19, 851. [Google Scholar] [CrossRef] [PubMed]
- Yoshida, S.; Hiraga, K.; Takehana, T.; Taniguchi, I.; Yamaji, H.; Maeda, Y.; Toyohara, K.; Miyamoto, K.; Kimura, Y.; Oda, K. A bacterium that degrades and assimilates poly(ethylene terephthalate). Science 2016, 351, 1196. [Google Scholar] [CrossRef]
- Kučić Grgić, D.; Miloloža, M.; Lovrinčić, E.; Kovačević, A.; Cvetnić, M.; Ocelić Bulatović, V.; Prevarić, V.; Bule, K.; Ukić, Š.; Markić, M.; et al. Bioremediation of MP-polluted waters using bacteria Bacillus licheniformis, Lysinibacillus massiliensis, and mixed culture of Bacillus sp. and Delftia acidovorans. Chem. Biochem. Eng. Q. 2021, 35, 205–224. [Google Scholar] [CrossRef]
- Malachová, K.; Novotný, Č.; Adamus, G.; Lotti, N.; Rybková, Z.; Soccio, M.; Šlosarčíková, P.; Verney, V.; Fava, F. Ability of Trichoderma hamatum isolated from plastics-polluted environments to attack petroleum-based synthetic polymer films. Processes 2020, 8, 467. [Google Scholar] [CrossRef]
- Munir, E.; Harefa, R.S.M.; Priyani, N.; Suryanto, D. Plastic degrading fungi Trichoderma viride and Aspergillus nomius isolated from local landfill soil in Medan. IOP Conf. Ser. Earth Environ. Sci. 2018, 126, 012145. [Google Scholar] [CrossRef]
- Tamnou, E.B.M.; Arfao, A.T.; Nougang, M.E.; Metsopkeng, C.S.; Ewoti, O.V.N.; Moungang, L.M.; Nana, P.A.; Takang-Etta, L.-R.A.; Perrière, F.; Sime-Ngando, T.; et al. Biodegradation of polyethylene by the bacterium Pseudomonas aeruginosa in acidic aquatic microcosm and effect of the environmental temperature. Environ. Chall. 2021, 3, 100056. [Google Scholar] [CrossRef]
- Zahari, N.Z.; Abdullah, S.N.; Tuah, P.M.; Cleophas, F.N. Biodegradation of low-density polyethylene (LDPE) and starch-based plastic (SBP) by thermophiles Bacillus subtilis and Candida tropicalis. IOP Conf. Ser. Mater. Sci. Eng. 2021, 1173, 012035. [Google Scholar] [CrossRef]
- Suresh, B.; Maruthamuthu, S.; Palanisamy, N.; Ragunathan, R.; Navaneetha Pandiyaraj, K.; Muralidharan, V.S. Investigation on biodegradability of polyethylene by Bacillus cereus strain Ma-Su isolated from compost soil. Res. J. Microbiol. 2001, 2, 292. [Google Scholar]
- Mukherjee, S.; Chaudhuri, U.R.; Kundu, P.P. Bio-degradation of polyethylene waste by simultaneous use of two bacteria: Bacillus licheniformis for production of bio-surfactant and Lysinibacillus fusformis for bio-degradation. RSC Adv. 2016, 6, 2982. [Google Scholar] [CrossRef]
- Das, M.P.; Kumar, S. Microbial deterioration of low density polyethylene by Aspergillus and Fusarium sp. Int. J. Chem. Technol. Res. 2014, 6, 299–305. [Google Scholar]
- Sindujaa, P.; Padmapriya, M.; Pramila, R.; Vijaya Ramesh, K. Bio-degradation of low density polyethylene (LDPE) by fungi isolated from marine water. Res. J. Biol. Sci. 2011, 6, 141–145. [Google Scholar] [CrossRef]
- Singh, J.; Gupta, K.C. Screening and identification of low density polyethylene (LDPE) degrading soil fungi isolated from polythene polluted sites around Gwalior city (M.P.). Int. J. Curr. Microbiol. Appl. Sci. 2014, 3, 443–448. [Google Scholar]
- Singh, V.; Dubey, M.; Bhadauria, S. Microbial degradation of polyethylene (low density) by Aspergillus fumigatus and Penicillium sp. Asian J. Exp. Biol. Sci. 2012, 3, 498–503. [Google Scholar]
- Coates, J. Interpretation of Infrared Spectra, A Practical Approach. In Encyclopedia of Analytical Chemistry; Meyers, R.A., Ed.; John Wiley & Sons: Chichester, NH, USA, 2000; pp. 10815–10837. [Google Scholar] [CrossRef]
- Tai, N.L.; Adhikari, R.; Shanks, R.; Adhikari, B. Aerobic biodegradation of starch–polyurethane flexible films under soil burial condition: Changes in physical structure and chemical composition. Int. Biodeterior. Biodegrad. 2019, 145, 104793. [Google Scholar] [CrossRef]
- Bode, H.B.; Zeeck, A.; Jendrossek, D. Physiological and chemical investigations into microbial degradation of synthetic poly(cis-1,4-isoprene). Appl. Environ. Microbiol. 2000, 66, 3680–3685. [Google Scholar] [CrossRef] [PubMed]
- Mooney, A.; Ward, P.G.; O’Connor, K.E. Microbial degradation of styrene: Biochemistry, molecular genetics, and perspectives for biotechnological applications. Appl. Microbiol. Biotechnol. 2006, 72, 1–10. [Google Scholar] [CrossRef] [PubMed]
- Slouf, M.; Synkova, H.; Baldrian, J.; Marek, A.; Kovarova, J.; Schmidt, P.; Dorschner, H.; Stephan, M.; Gohs, U. Structural changes of UHMWPE after e-beam irradiation and thermal treatment. J. Biomed. Mater. Res. Part B Appl. Biomater. 2008, 85B, 240–251. [Google Scholar] [CrossRef] [PubMed]
- Slouf, M.; Michalkova, D.; Gajdosova, V.; Dybal, J.; Pilar, J. Prooxidant activity of phenolic stabilizers in polyolefins during accelerated photooxidation. Polym. Degrad. Stab. 2019, 166, 307–324. [Google Scholar] [CrossRef]
- Kim, H.R.; Lee, H.M.; Yu, H.C.; Jeon, E.; Lee, S.; Li, J.; Kim, D.H. Biodegradation of polystyrene by Pseudomonas sp. isolated from the gut of superworms (larvae of Zophobas atratus). Environ. Sci. Technol. 2020, 54, 6987–6996. [Google Scholar] [CrossRef]
- Pilar, J.; Michalkova, D.; Slouf, M.; Vackova, T. Long-term accelerated weathering of HAS stabilized PE and PP plaques: Compliance of ESRI, IR and MH data characterizing heterogeneity of photooxidation. Polym. Degrad. Stab. 2015, 120, 114–121. [Google Scholar] [CrossRef]

| Experiment | Media of Isolated Microorganisms | Polymer Material | m0 (Polymer)/g | CFUbacteria | CFUfungi |
|---|---|---|---|---|---|
| E1-1 | Activated sludge and river sediment | LDPE | 0.1115 | 2.7 × 106 | 3.3 × 106 |
| E1-2 | TPS | 0.1080 | |||
| E1-3 | LDPE+20%TPS | 0.1424 | |||
| E1-4 | LDPE+20%TPS+SEBS | 0.1287 | |||
| E2-1 | Compost | LDPE | 0.0959 | 4.1 × 106 | 2.9 × 106 |
| E2-2 | TPS | 0.1381 | |||
| E2-3 | LDPE+20%TPS | 0.1770 | |||
| E2-4 | LDPE+20%TPS+SEBS | 0.1245 |
| Isolates | Group of Microorganisms | Sample | Identified Microorganisms |
|---|---|---|---|
| I1 | bacteria | compost | Bacillus sonorensis |
| I2 | Bacillus subtilis | ||
| I3 | activated sludge | Lysinibacillus massiliensis | |
| I4 | sediment | Bacillus licheniformis | |
| I5 | Bacillus indicus | ||
| I6 | Bacillus megaterium | ||
| I7 | activated sludge | Bacillus cereus | |
| I8 | sediment | Pseudomonas alcaligenes | |
| I9 | mold | sediment | Aspergillus sp. 1 (probably fumigatus) |
| I10 | compost | Aspergillus sp. 2 (probably niger) | |
| I11 | Trichoderma sp. | ||
| I12 | Rhizopus sp. | ||
| I13 | sediment | Penicillium sp. | |
| I14 | activated sludge | Alternaria sp. | |
| I15 | yeast | sediment | Candida parapsilosis |
| Isolates | Morphology of Isolated Colonies |
|---|---|
| I1 | Yellowish with flat elevation and irregular edges, rod shaped |
| I2 | White to slightly yellow, mucous, and flat with regular round configuration, rod shaped |
| I3 | White colonies with yellowish edges, mucous, shiny, and round configuration, rod shaped |
| I4 | White yellowish colonies, round and flat with jagged edges, rod shaped |
| I5 | Yellowish-orange colonies with regular round configuration, mucous and shiny, rod shaped |
| I6 | Yellowish to slightly brown colonies with round configuration, rod shaped |
| I7 | Large white to slightly grey, opaque colonies with jagged margins, rod shaped |
| I8 | Pale yellowish colonies, mucous with regular round configuration, rod shaped |
| I9 | Greyish green, rough with white center, septate hyphae, and black head |
| I10 | Formed black colonies with arachnoid structure, non-septate hyphae, black spores, and head from which spores are spreading radiate |
| I11 | Greenish with white arachnoid structure and widespread colony, septate hyphae, and head in the shape of flower |
| I12 | Greyish colonies with black center, false roots, non-septate hyphae and bow-shaped head |
| I13 | Colonies were greyish green, round configuration with white center, septate hyphae, and broom-shaped head |
| I14 | Black colonies arachnoid structure with white center, specific conidia, and septate hyphae |
| I15 | White, creamy, shiny, and very small with round configuration, cells were oval or round with pseudohyphae |
| Isolate | Gram Staining | KOH Test | Ziehl-Nielson Staining | Schaffer-Fulton Staining | Negative Staining | Motility | Oxidase | Catalase | Nitrate-Reductase |
|---|---|---|---|---|---|---|---|---|---|
| I1 | +ve | − | + | + | +/− | + | + | + | + |
| I2 | +ve | − | − | + | +/− | + | + | + | + |
| I3 | +ve | − | + | + | +/- | + | + | + | − |
| I4 | +ve | − | +/− | + | +/− | + | + | + | + |
| I5 | +ve | − | + | + | +/− | + | − | +/− | − |
| I6 | +ve | − | + | + | +/− | + | + | + | − |
| I7 | +ve | − | +/− | + | − | + | + | − | + |
| I8 | −ve | + | − | − | − | + | + | + | + |
| Experiment | Polymer Material | m0 (Polymer)/g | m56 (Polymer)/g | WL/% |
|---|---|---|---|---|
| E1-1 | LDPE | 0.1115 | 0.1078 | 3.3184 |
| E1-2 | TPS | 0.1080 | 0.0000 | 100.00 |
| E1-3 | LDPE+20%TPS | 0.1424 | 0.1223 | 14.1152 |
| E1-4 | LDPE+20%TPS+SEBS | 0.1287 | 0.1081 | 16.0062 |
| E2-1 | LDPE | 0.0959 | 0.0921 | 3.9625 |
| E2-2 | TPS | 0.1381 | 0.0000 | 100.00 |
| E2-3 | LDPE+20%TPS | 0.1770 | 0.1408 | 20.4520 |
| E2-4 | LDPE+20%TPS+SEBS | 0.1245 | 0.0972 | 21.9277 |
Disclaimer/Publisher’s Note: The statements, opinions and data contained in all publications are solely those of the individual author(s) and contributor(s) and not of MDPI and/or the editor(s). MDPI and/or the editor(s) disclaim responsibility for any injury to people or property resulting from any ideas, methods, instructions or products referred to in the content. |
© 2023 by the authors. Licensee MDPI, Basel, Switzerland. This article is an open access article distributed under the terms and conditions of the Creative Commons Attribution (CC BY) license (https://creativecommons.org/licenses/by/4.0/).
Share and Cite
Kučić Grgić, D.; Miloloža, M.; Ocelić Bulatović, V.; Ukić, Š.; Slouf, M.; Gajdosova, V. Screening the Efficacy of a Microbial Consortium of Bacteria and Fungi Isolated from Different Environmental Samples for the Degradation of LDPE/TPS Films. Separations 2023, 10, 79. https://doi.org/10.3390/separations10020079
Kučić Grgić D, Miloloža M, Ocelić Bulatović V, Ukić Š, Slouf M, Gajdosova V. Screening the Efficacy of a Microbial Consortium of Bacteria and Fungi Isolated from Different Environmental Samples for the Degradation of LDPE/TPS Films. Separations. 2023; 10(2):79. https://doi.org/10.3390/separations10020079
Chicago/Turabian StyleKučić Grgić, Dajana, Martina Miloloža, Vesna Ocelić Bulatović, Šime Ukić, Miroslav Slouf, and Veronika Gajdosova. 2023. "Screening the Efficacy of a Microbial Consortium of Bacteria and Fungi Isolated from Different Environmental Samples for the Degradation of LDPE/TPS Films" Separations 10, no. 2: 79. https://doi.org/10.3390/separations10020079
APA StyleKučić Grgić, D., Miloloža, M., Ocelić Bulatović, V., Ukić, Š., Slouf, M., & Gajdosova, V. (2023). Screening the Efficacy of a Microbial Consortium of Bacteria and Fungi Isolated from Different Environmental Samples for the Degradation of LDPE/TPS Films. Separations, 10(2), 79. https://doi.org/10.3390/separations10020079

